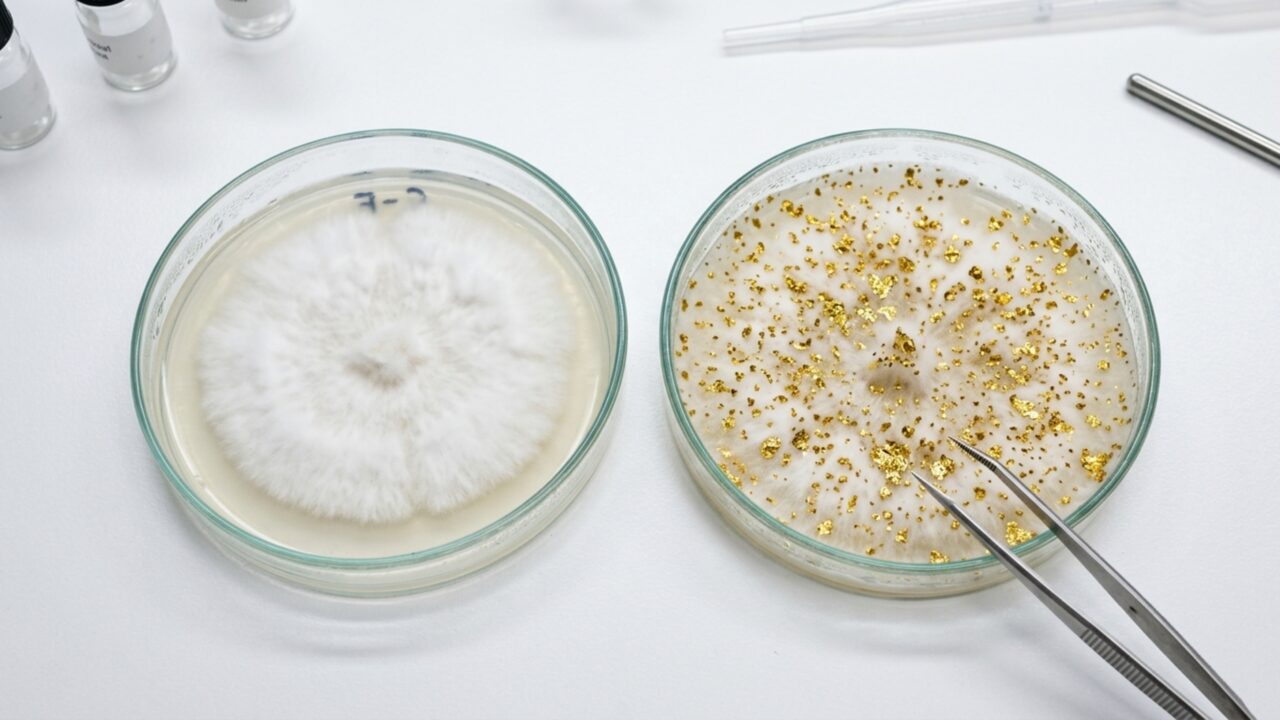
Cientistas não acreditam: descoberto fungo capaz de "fabricar" ouro que você pode ter em casa

Cientistas não acreditam: descoberto fungo capaz de “fabricar” ouro que você pode ter em casa
Como um fungo comum utiliza o ouro para prosperar e o que a ciência aprendeu desde 2019.
Em 2019, pesquisadores da agência científica australiana CSIRO publicaram um estudo que deixou o mundo boquiaberto: um fungo comum no solo, o Fusarium oxysporum, é capaz de acumular partículas de ouro em sua superfície. Mas a descoberta não é exatamente o que as manchetes sensacionalistas andam anunciando.
Que fungo é esse que interage com ouro?
O protagonista da história é o Fusarium oxysporum, um fungo filamentoso amplamente distribuído em solos do mundo inteiro. Ele é mais conhecido dos agricultores por causar a murcha em culturas como tomate, banana e algodão.
O que ninguém esperava é que, em solos ricos em metais, esse mesmo fungo fosse capaz de interagir quimicamente com o ouro. A descoberta aconteceu em Boddington, uma região de mineração a 130 quilômetros de Perth, no oeste da Austrália.
O fungo realmente “fabrica” ouro?
Não. E essa é a parte mais importante da história. O Fusarium oxysporum não cria ouro a partir do nada, como um alquimista microscópico. O que ele faz é dissolver e precipitar ouro que já existe no ambiente ao seu redor.
O processo funciona em duas etapas: primeiro, o fungo libera uma substância chamada superóxido, que dissolve partículas minúsculas de ouro presentes no solo. Depois, ele precipita esse ouro dissolvido novamente em forma sólida, criando nanopartículas que se fixam em suas hifas.
Quem descobriu esse fenômeno e como?
O estudo foi liderado pelo geomicrobiólogo Tsing Bohu, pesquisador da CSIRO, e publicado na revista Nature Communications em 2019. A equipe coletou amostras de solo em uma mina de ouro e cultivou fungos em laboratório.
Os resultados surpreenderam até os próprios cientistas. Diferentemente das bactérias, que já eram conhecidas por interagir com metais, nunca se havia observado fungos fazendo o mesmo com ouro. O metal é tão quimicamente inerte que a interação parecia improvável.
Por que o fungo faz isso? Existe alguma vantagem?
Sim, e essa foi outra descoberta intrigante da pesquisa. As colônias de fungos que acumulam ouro crescem mais rápido e se espalham com maior eficiência do que aquelas que não interagem com o metal.
A hipótese dos cientistas é que o ouro atua como uma espécie de catalisador, ajudando o fungo a digerir certas formas de carbono presentes no solo. Em outras palavras, revestir-se de ouro traz um benefício biológico real para o microrganismo.
É possível cultivar esse fungo em casa e “produzir” ouro?
A resposta curta é não, pelo menos não no sentido que as manchetes sugerem. O fungo só realiza esse processo se houver ouro dissolvido no ambiente. Se o solo do seu quintal não estiver sobre uma jazida aurífera, nada vai acontecer.
Mesmo quando o fungo encontra ouro, a quantidade produzida é microscópica. Os pesquisadores alertam que as partículas só podem ser vistas com microscópio eletrônico. Nenhum experimento conseguiu escalar o processo para algo comercialmente viável.
| Ponto | Realidade |
|---|---|
| Produzir ouro em casa | Não é possível |
| Condição obrigatória para o processo | Ouro dissolvido no ambiente |
| Solo sem jazida aurífera | Nenhuma partícula é produzida |
| Quantidade gerada pelo fungo | Microscópica, visível só em microscópio eletrônico |
| Viabilidade comercial | Nenhum experimento conseguiu escalar o processo |
Quais os riscos de manipular esse fungo em casa?
Cultivar Fusarium oxysporum fora do laboratório não é uma ideia recomendada. O fungo é um patógeno agrícola conhecido, capaz de causar doenças em mais de 100 espécies de plantas, incluindo culturas de importância econômica.
Além disso, alterar o equilíbrio de microrganismos no solo pode gerar efeitos ecológicos imprevisíveis. Os cuidados necessários incluem:
- Ambiente com temperatura e umidade rigidamente controladas
- Substrato que contenha minerais com traços de ouro
- Protocolos de biossegurança para evitar contaminação ambiental
Qual é a utilidade real dessa descoberta?
A aplicação mais promissora não é produzir ouro em casa, mas sim usar o fungo como bioindicador geológico. Onde há Fusarium oxysporum interagindo com ouro, pode haver uma jazida relevante abaixo da superfície.
Pesquisadores também investigam se microrganismos semelhantes podem ser usados na biorremediação, recuperando metais valiosos de resíduos eletrônicos e efluentes de mineração. Ainda assim, são aplicações em estágio inicial, que dependem de muitos anos de pesquisa para sair do laboratório.
Os comentários não representam a opinião do site; a responsabilidade pelo conteúdo postado é do autor da mensagem.
Comentários (0)